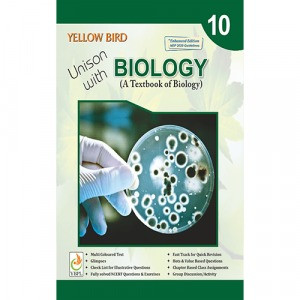
biologyclass10book.jpg

Science is best understood through observation and experimentation. The Class 10 Science Lab Manual is designed to help students apply theoretical concepts in a hands-on learning environment. By conducting experiments in Physics, Chemistry, and Biology, students can strengthen their understanding, improve analytical skills, and enhance their problem-solving abilities. Yellow Bird Publications offers a well-structured Science Lab Manual for Class 10, making practical learning simple and effective.
Why is a Science Lab Manual Important?
A lab manual is an essential companion for students, guiding them through experiments in a systematic manner. It helps students:
✔ Develop a scientific approach by observing and analyzing real-life phenomena.
✔ Understand theoretical concepts through hands-on activities.
✔ Improve experimental skills and learn to record accurate observations.
✔ Prepare effectively for practical exams with step-by-step instructions.
Key Features of Our Class 10 Science Lab Manual
-
Detailed Step-by-Step Instructions
- Clear explanations for conducting experiments with accuracy.
-
Well-Illustrated Diagrams & Graphs
- Visual representations for easy understanding and correct setup.
-
Precautionary Measures & Safety Tips
- Guidelines to ensure safe and efficient execution of experiments.
-
Observation Tables & Sample Readings
- Helps students record data correctly and interpret results effectively.
-
Viva Questions & Self-Assessment Tests
- Practice questions to prepare for oral and written practical exams.
-
Covers Entire Science Syllabus
- Designed as per the latest curriculum for Physics, Chemistry, and Biology.
Experiments Covered in the Class 10 Science Lab Manual
🔹 Physics – Laws of Reflection, Ohm’s Law, Refraction through Lenses, Magnetic Effects of Current.
🔹 Chemistry – pH Experiments, Reactions of Acids & Bases, Types of Chemical Reactions, Metal & Non-Metal Reactions.
🔹 Biology – Study of Plant Tissues, Osmosis in Living Cells, Food Tests, Human Digestive System Model.
How This Book Helps Students?
✔ Enhances Practical Knowledge – Strengthens conceptual clarity with hands-on experience.
✔ Boosts Exam Confidence – Helps students score well in school practical assessments.
✔ Encourages Scientific Curiosity – Develops problem-solving and analytical thinking.
✔ Ensures Accurate Observations – Teaches correct methods of data collection and interpretation.
Conclusion
The Class 10 Science Lab Manual is an invaluable resource for students looking to master practical experiments. With structured activities, safety tips, and exam-oriented content, this manual makes learning Science interactive, engaging, and effective.
Explore the world of Science through experiments and discoveries—learn better with
! 🚀🔬